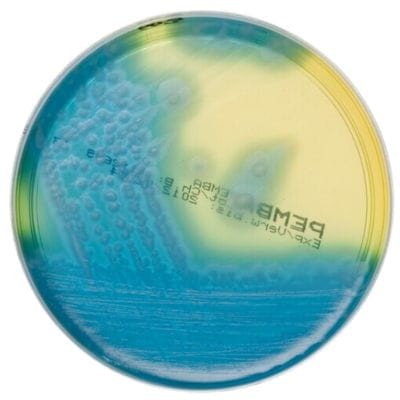
Bacillus_cereus_Selective_Agar_gotowa_pożywka_na_płytkach_Bestlabs.jpg

Bacillus cereus Selective Agar (PEMBA) gotowa pożywka na płytkach do izolacji Bacillus cereus
• Opakowanie: 10 szt.
• Płytka: 90 mm.
• Do izolacji Bacillus cereus.
• Wyrób medyczny: Tak.
 Opis
Opis
Bacillus cereus Selective Agar (PEMBA) – gotowa pożywka na płytkach do izolacji Bacillus cereus
Bacillus cereus Selective Agar (PEMBA) to gotowe podłoże mikrobiologiczne opracowane do selektywnej izolacji i liczenia Bacillus cereus z próbek żywności. Dzięki zaawansowanej formule, która łączy selektywność i właściwości diagnostyczne, pożywka Thermo Scientific™ Oxoid™ Polymyxin Egg Yolk Mannitol Bromothymol Blue Agar (PEMBA) zapewnia precyzyjne wyniki nawet w przypadku próbek o wysokim stopniu zanieczyszczenia.
Zastosowanie Bacillus cereus Selective Agar (PEMBA)
Izolacja Bacillus cereus z próbek żywności
Podłoże PEMBA zostało zaprojektowane do zastosowań w analizach mikrobiologicznych próbek żywności, gdzie konieczne jest wykrycie i oznaczenie liczby komórek oraz zarodników bakterii Bacillus cereus.
Precyzyjna diagnostyka
Podłoże umożliwia łatwą identyfikację kolonii Bacillus cereus dzięki ich charakterystycznym cechom, co czyni je odpowiednim narzędziem do analiz laboratoryjnych wymagających szybkich i dokładnych wyników.
Specyfikacja produktu
Parametry techniczne
- Opakowanie: 10 sztuk gotowych do użycia płytek.
- Średnica płytki: 90 mm.
- Zastosowanie: Selektywna izolacja Bacillus cereus z próbek żywności.
Cechy podłoża
- Polymyxin Egg Yolk Mannitol Bromothymol Blue Agar (PEMBA): Połączenie składników selektywnych, diagnostycznych i wskaźnikowych dla precyzyjnych wyników badań.
- Zgodność z normą ISO: Produkt testowany zgodnie z normą ISO11133:2014, co gwarantuje najwyższą jakość w badaniach mikrobiologicznych.
Cechy i zalety produktu
1. Wysoka selektywność
Podłoże jest wystarczająco selektywne, aby umożliwić izolację i liczenie niewielkich ilości Bacillus cereus w obecności innych mikroorganizmów, które mogą znajdować się w próbkach żywności.
2. Łatwa identyfikacja kolonii
Kolonie Bacillus cereus przyjmują charakterystyczny wygląd, co pozwala na ich szybką identyfikację bez konieczności stosowania skomplikowanych metod dodatkowych.
3. Zgodność z międzynarodowymi normami
Pożywka została przetestowana zgodnie z ISO11133:2014, co gwarantuje jej niezawodność i zgodność z wymaganiami dotyczącymi badań jakości żywności.
4. Połączenie selektywności i diagnostyki
Dzięki obecności takich składników jak polimyksyna i żółtko jajka, podłoże skutecznie eliminuje konkurencyjne mikroorganizmy, jednocześnie umożliwiając wyraźne różnicowanie Bacillus cereus od innych bakterii.
Instrukcja stosowania Bacillus cereus Selective Agar (PEMBA)
Przygotowanie próbek
- W warunkach aseptycznych otwórz opakowanie z płytkami.
- Przygotuj próbki żywności zgodnie z wymaganiami normy ISO lub procedurami laboratoryjnymi.
- Posiej próbkę na powierzchnię podłoża, stosując odpowiednią technikę rozprowadzenia materiału badawczego.
Inkubacja
- Inkubuj płytki w temperaturze 30°C ± 2°C przez 18–24 godziny.
- Przedłuż inkubację do 48 godzin w przypadku próbek o niskiej liczbie bakterii Bacillus cereus.
Interpretacja wyników
- Kolonie Bacillus cereus: Charakterystyczne różowe do czerwonych kolonie otoczone mętnością w wyniku hydrolizy żółtka.
- Inne mikroorganizmy: Brak wzrostu lub inny wygląd kolonii.
Dlaczego warto wybrać Bacillus cereus Selective Agar (PEMBA)?
- Precyzyjna izolacja: Wysoka selektywność podłoża pozwala na wykrycie Bacillus cereus nawet w próbkach z dużą ilością zanieczyszczeń.
- Diagnostyczna pewność: Wyraźne różnice wizualne między Bacillus cereus a innymi mikroorganizmami umożliwiają szybkie potwierdzenie wyników.
- Zgodność z normami ISO: Produkt spełnia najwyższe standardy jakości, co czyni go idealnym wyborem do analiz mikrobiologicznych żywności.
- Gotowość do użycia: Brak konieczności przygotowywania podłoża w laboratorium oszczędza czas i redukuje ryzyko błędów.
Podsumowanie
Bacillus cereus Selective Agar (PEMBA) to niezawodne i precyzyjne narzędzie do izolacji i liczenia Bacillus cereus z próbek żywności. Dzięki wyjątkowej selektywności, diagnostycznym właściwościom oraz zgodności z normami ISO11133:2014, produkt gwarantuje najwyższą jakość i dokładność w analizach mikrobiologicznych.
__________________________________________________________________________________________________________________________________________________________________________________________
Jest to wyrób medyczny.
Wyrób medyczny przeznaczony wyłącznie do użytku profesjonalnego, zgodnie z definicją zawartą w art. 2 pkt 1.26 Ustawy o wyrobach medycznych. Produkty te nie są przeznaczone do stosowania w warunkach domowych. Zakupu mogą dokonać jedynie osoby posiadające Prawo Wykonywania Zawodu (PWZ) lub firmy, podając numer NIP podczas składania zamówienia. W przypadku zamówienia złożonego przez użytkownika domowego, zostanie ono anulowane, a ewentualna wpłata zwrócona na konto klienta.
__________________________________________________________________________________________________________________________________________________________________________________________
W powyższym linku znajdą Państwo bazę aktualnych certyfikatów firmy OXOID. Wystarczy wpisać numer LOT zamówionej przez Państwa partii, w celu uzyskania odpowiedniego certyfikatu.
 Koszty dostawy
Cena netto, nie zawiera podatku
Koszty dostawy
Cena netto, nie zawiera podatku
darmowa i wygodna wysyłka
już od 800 zł netto
Najwyższa jakość
produktów potwierdzona certyfikatami
Zakupy 24h na dobę
wygodne i bezpieczne
bezpłatna konsultacja
z ekspertem online